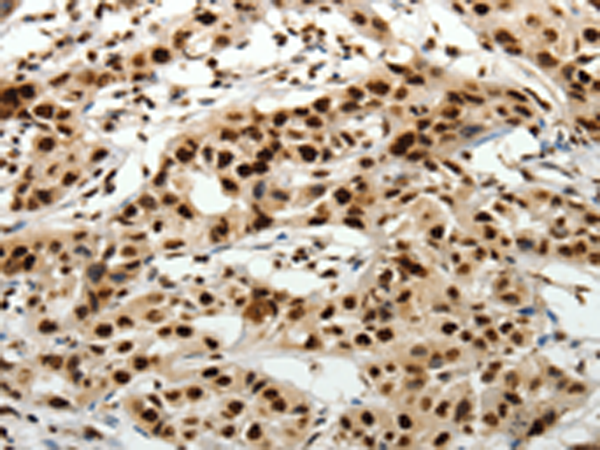

别名:FEB3; FHM3; NAC1; SCN1; SMEI; EIEE6; FEB3A; HBSCI; GEFSP2; Nav1.1应用:IHC
反应种属:Human, Rat
规格:50μl/100μl
| Description |
|---|
| The vertebrate sodium channel is a voltage-gated ion channel essential for the generation and propagation of action potentials, mainly in nerve and muscle. Voltage-sensitive sodium channels are heteromeric complexes consisting of a large central pore-forming glycosylated alpha subunit, and two smaller auxiliary beta subunits. This gene encodes the large alpha subunit, and mutations in this gene have been associated with several epilepsy, convulsion and migraine disorders. Alternative splicing results in multiple transcript variants. The RefSeq Project has decided to create four representative RefSeq records. Three of the transcript variants are supported by experimental evidence and the fourth contains alternate 5′ untranslated exons, the exact combination of which have not been experimentally confirmed for the full-length transcript. |
| Specification | |
|---|---|
| Aliases | FEB3; FHM3; NAC1; SCN1; SMEI; EIEE6; FEB3A; HBSCI; GEFSP2; Nav1.1 |
| Swissprot | P35498 |
| Host/Isotype | Rabbit IgG |
| Storage | Store at 4°C short term. Aliquot and store at -20°C long term. Avoid freeze/thaw cycles. |
| Species Reactivity | Human, Rat |
| Immunogen | Synthetic peptide of human SCN1A |
| Formulation | pH7.4 PBS, 0.05% NaN3, 40% Glycerol |
| Application | |
|---|---|
| IHC | 1/50-1/200 |
| ELISA | 1/2000-1/5000 |
![]() |
The image is immunohistochemistry of paraffin-embedded Human cervical cancer tissue using P04440(SCN1A Antibody) at dilution 1/40. (Original magnification: ×200) |
![]() |
The image is immunohistochemistry of paraffin-embedded Human lung cancer tissue using P04440(SCN1A Antibody) at dilution 1/40. (Original magnification: ×200) |
本公司的所有产品仅用于科学研究或者工业应用等非医疗目的,不可用于人类或动物的临床诊断或治疗,非药用,非食用。
暂无评论
本公司的所有产品仅用于科学研究或者工业应用等非医疗目的,不可用于人类或动物的临床诊断或治疗,非药用,非食用。
中文

发表回复